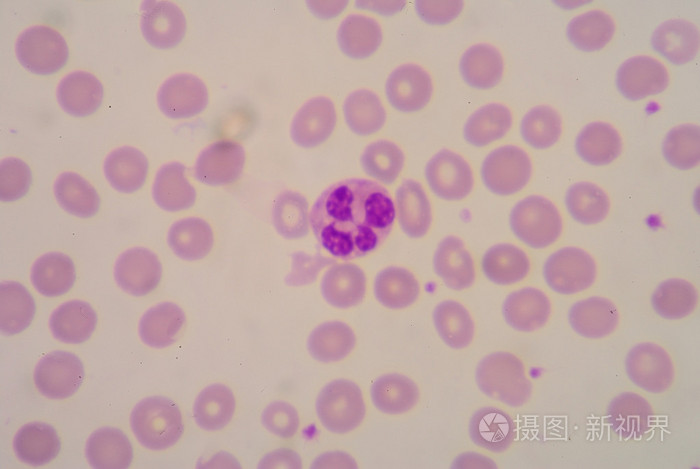
中性粒细胞
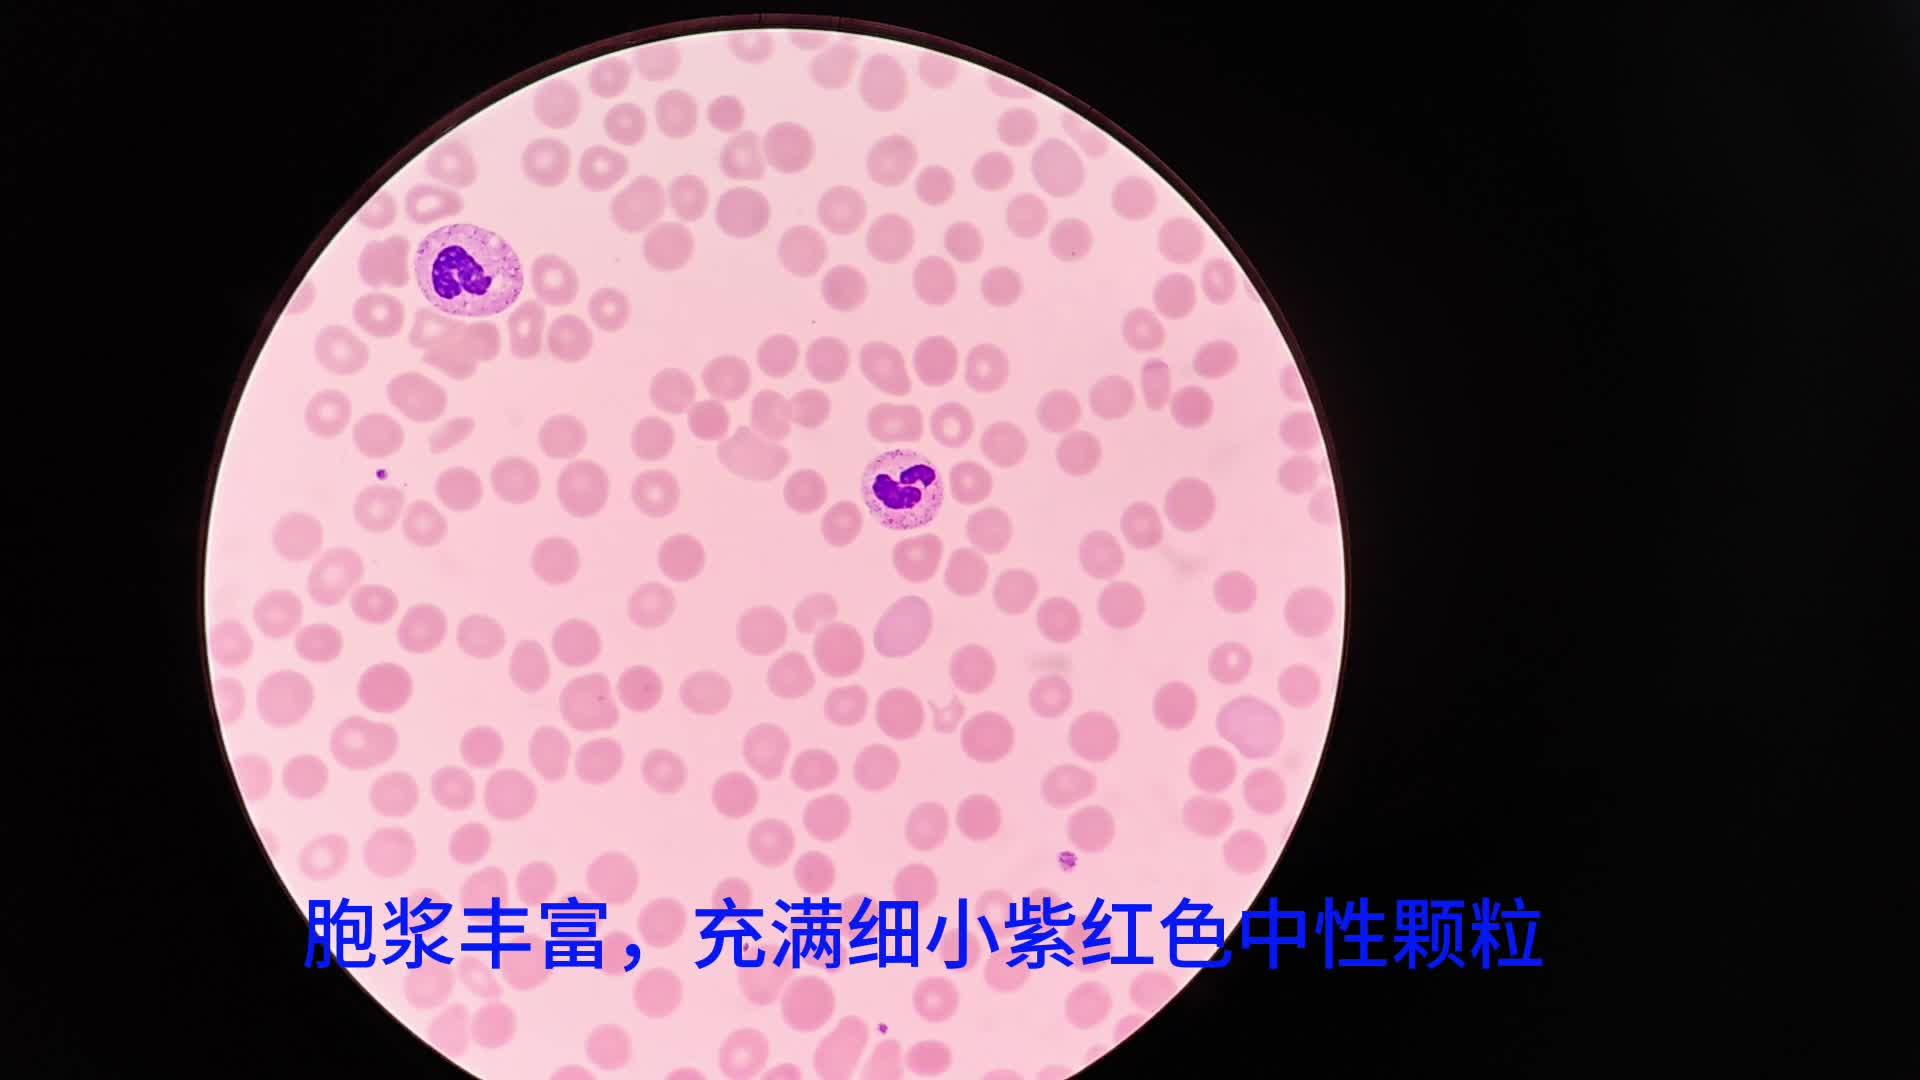
中性粒细胞在显微镜下的主要特征在非特异性免疫应答中起什么作用

中性粒细胞

中性粒细胞
图片尺寸685x1023中性粒细胞胞
图片尺寸1200x900
中性粒细胞:人类身体内的微型84消毒液工厂
图片尺寸500x434
中性粒细胞毒性变化
图片尺寸660x533
中性粒细胞.#上热门话题 #抖音图文涨知识 #医学科普 - 抖音
图片尺寸1440x1566
中性粒细胞毒性变化
图片尺寸660x533
中性粒细胞
图片尺寸1500x1500
儿童中性粒细胞百分比偏低是什么原因导致的
图片尺寸941x941
中性粒细胞
图片尺寸700x469
hypersegmented 中性粒细胞.
图片尺寸352x300中性粒细胞胞
图片尺寸800x1200中性粒细胞胞
图片尺寸900x1200中性粒细胞高说明什么(血常规检查中) - 百百科
图片尺寸1280x960
中性粒细胞偏低
图片尺寸410x220
中性粒细胞毒性变化
图片尺寸660x533
淋巴细胞 红细胞 血细胞 单核细胞 白细胞 血小板 中性粒细胞 嗜酸性
图片尺寸1080x810
中性粒细胞偏高是什么意思死而后已白细胞中性粒细胞
图片尺寸3024x3024中性粒细胞血细胞
图片尺寸1200x748
中性粒细胞在显微镜下的主要特征在非特异性免疫应答中起什么作用
图片尺寸1920x1080
显微镜下中性粒细胞图片
图片尺寸400x300
猜你喜欢:中性粒细胞 工作细胞五种白细胞形态图分辨中性粒细胞染色后图片中性细胞中性粒细胞偏高中性粒细胞英文缩写中性粒细胞分叶核吞噬细胞 显微镜中性粒细胞下降中性中幼粒细胞rs细胞中幼红细胞中幼粒细胞nk细胞树突状细胞单核巨噬细胞嗜酸性粒细胞手绘图中性分叶核粒细胞纤维细胞大淋巴细胞嗜碱性细胞巨噬细胞吞噬鸡红细胞嗜酸细胞自然杀伤细胞上皮样细胞中性粒细胞镜下图片单核细胞镜下图片杀手t细胞x白细胞r18图五种白细胞肥大细胞阿夸表情包肖战奶萌壁纸速度与激情拉姆齐微信九宫格 空白配图2019gifyear沈白高铁通化段线路图在家给女儿剪头发步骤消防通道字体模板王者荣耀庄周 动漫北影学生明星中国美术学院静物素描绅士情侣头像一男一女